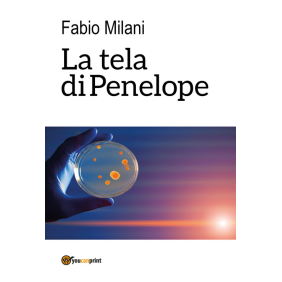

La tela di Penelope
- Autore/i.................: Milani Fabio
- Anno Edizione......: 2017
- EAN.........................: 9788892686052
- Editore....................: Youcanprint
- Collana...................: Youcanprint Self-Publishing
- Pagine.....................: 512
25,00 €
Tasse incluse
Dagli sfarzosi giardini del Mirabell di Salisburgo alla sede dell'Organizzazione Mondiale della Sanità a Ginevra, dal quartier generale dei Navy Seal a Little Creek alle anonime casseforti societarie di Vanuatu, dallo smog del quartiere degli affari d'Hong Kong alla rigogliosa natura della California, dal lusso degli hotel di Dubai alla nebbia della campagna inglese, "La tela di Penelope" getta uno sguardo attento sulle inquietanti zone d'ombra delle speculazioni finanziarie, della ricerca sanitaria, dei paradisi finanziari mondiali, e sui legami tra terrorismo e interessi economici. Le debolezze umane, le vulnerabilità d'ognuno, la fragilità della vita corrono tra le righe di questo romanzo dove personaggi, istituzioni, luoghi e figure pubbliche mostrano il loro lato debole, quel punto critico in cui il male può insinuarsi e mettere in crisi un intero sistema, alterandone il funzionamento in maniera tanto minima da risultare invisibile, ma tanto perfetta da causarne il collasso.
Commenti Nessun cliente per il momento.